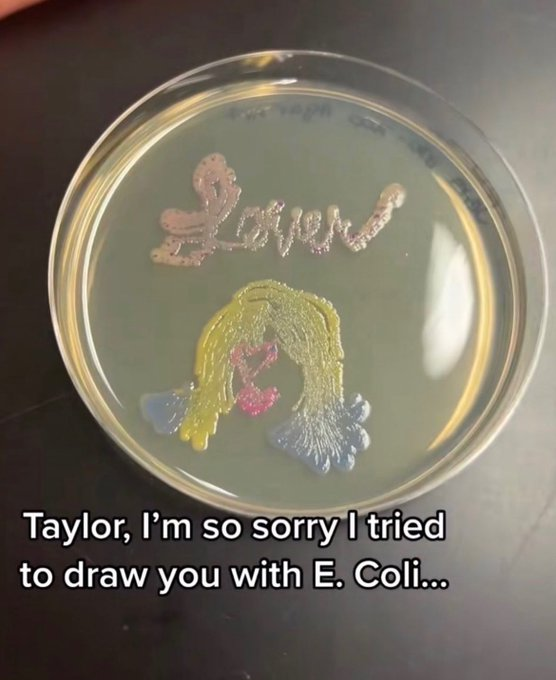
Interesting As Fuck (@interesting_ail) on Twitter photo

Zoe Jerke
@zoejerke22
Mac vb ‘25
ID: 721108990864678913
15-04-2016 22:52:35
361 Tweet
329 Takipçi
340 Takip Edilen












So thankful to be top ten in the class of 2027 rankings, and blessed to be considered 1 on the initial list!! Appreciate you DeckScoutKS… So many good players on the list, including my teammates Sofie Simic and Bella Cook!! #classof2027


Good Luck at Nationals to McPherson College XCTF Charity Williams in the 100m Hurdles! #BulldogPride #skodogs




Get out the brooms! McPherson Volleyball takes down No. 21-ranked Montana Tech 3-0! The Bulldogs hit .340 as a team with three blocks and 45 kills #BulldogPride #skodogs


Make that two sweeps on the day for McPherson Volleyball! The Bulldogs are back in action tomorrow at 11:30 AM against Grand View #BulldogPride #skodogs